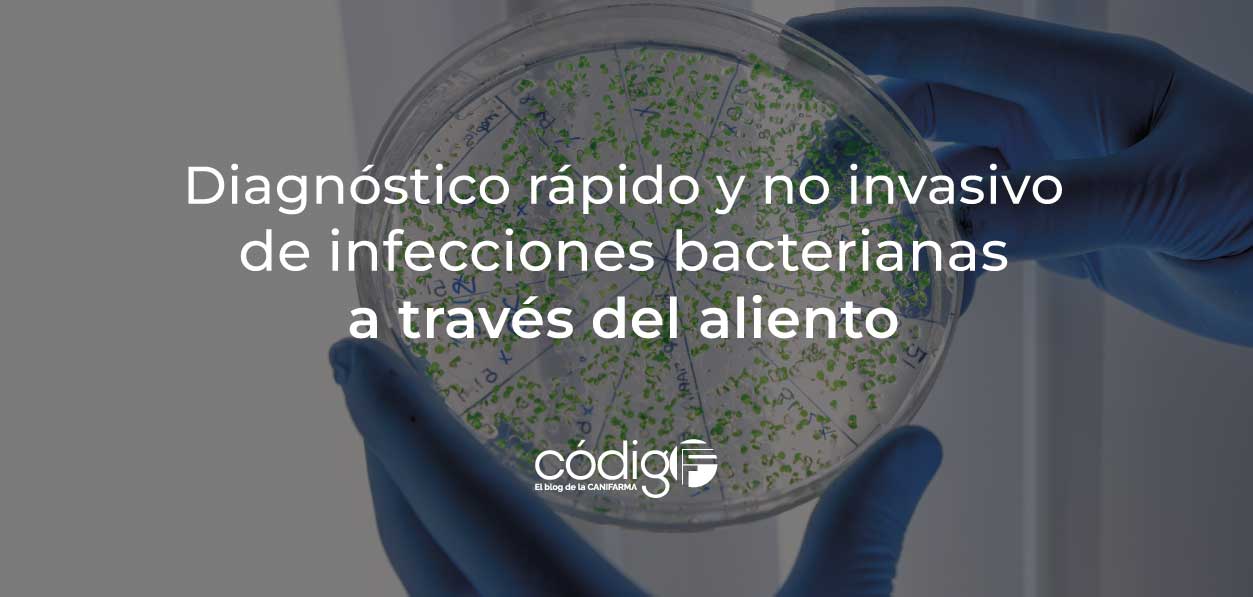
Diagnóstico rápido y no invasivo de infecciones bacterianas a través del aliento

Los resultados del estudio abren la posibilidad de poner al alcance médico una prueba segura, sencilla, de fácil acceso y económica, para detectar rápidamente infecciones bacterianas
Es bien sabido que un diagnóstico oportuno, seguido de una o varias acciones terapéuticas precisas, son la avanzada que potencialmente permitirá a los médicos ofrecer a sus pacientes mayores posibilidades de recuperación o, cuando menos, de conseguir una mejor calidad de vida.
En este campo, la distinción precisa y rápida entre infecciones bacterianas invasivas, enfermedades virales y afecciones no infecciosas continúa siendo un desafío crítico en la medicina clínica. Para ello, los médicos utilizan cultivos de sangre que, si bien es cierto que ofrecen gran precisión, pueden demorar varios días en ofrecer resultados; o la realización de pruebas moleculares, que lamentablemente no siempre están disponibles, sobre todo en clínicas ubicadas en poblaciones pequeñas.
En este contexto, dos equipos de investigadores trabajando al alimón, uno de la Universidad de California, en San Francisco, y otro del Hospital St. Jude, en Memphis, ambos en los EE. UU., desarrollaron un sistema de diagnóstico rápido, eficiente y sencillo, que al hacer pasar el aliento de una persona a través de un dispositivo portátil y económico es capaz de determinar la presencia de uno o más patógenos, utilizando uno o más metabolitos enriquecidos con 13C para ese fin específico.
Los resultados de la investigación se publicaron el pasado 18 de marzo en la revista ACS Central Science, bajo el título: “Detecting Bacteria in Their Mammalian Hosts Using Metabolism-Targeted [13C]CO2 Breath Testing” (Detección de bacterias en sus huéspedes mamíferos mediante pruebas de aliento con [ 13C ]CO2 dirigidas al metabolismo).
“Un paciente puede quejarse de síntomas inespecíficos, como dolor e hinchazón, pero probablemente se trate de una crisis vasooclusiva, puramente inflamatoria. Sin embargo, podría ser una infección, y dado que el riesgo de no detectarla es alto, se les administran antibióticos de todos modos, incluso cuando no son necesarios”. Doctor en Medicina Kiel Neumann del Departamento de Radiología del St. Jude Children´s Research Hospital
Gracias a este innovador y sorprendente sistema de diagnóstico por aliento, además de la detección de la infección, se puede identificar su localización y la respuesta a la terapia antimicrobiana.
Hasta el momento, la prueba se ha realizado únicamente en roedores de laboratorio, pero los resultados obtenidos son un paso firme hacia el desarrollo de una medicina cada vez más personalizada, y al manejo responsable de los recursos antimicrobianos, los cuales enfrentan serias resistencias que disminuyen su eficacia.
Por: Manuel Garrod, miembro del Comité Editorial de códigoF
Fuentes:
![]() ACS Central Science. (18 de marzo de 2026).
ACS Central Science. (18 de marzo de 2026).
Detecting Bacteria in Their Mammalian Hosts Using Metabolism-Targeted [13C]CO2 Breath Testing.
![]() St. Jude Children´s Research Hospital. (18 de marzo de 2026).
St. Jude Children´s Research Hospital. (18 de marzo de 2026).
Study shows breath test can confirm bacterial infection.
![]() ELSEVIER. (Agosto de 2025).
ELSEVIER. (Agosto de 2025).
Pruebas de aliento en el diagnóstico de enfermedades digestivas.